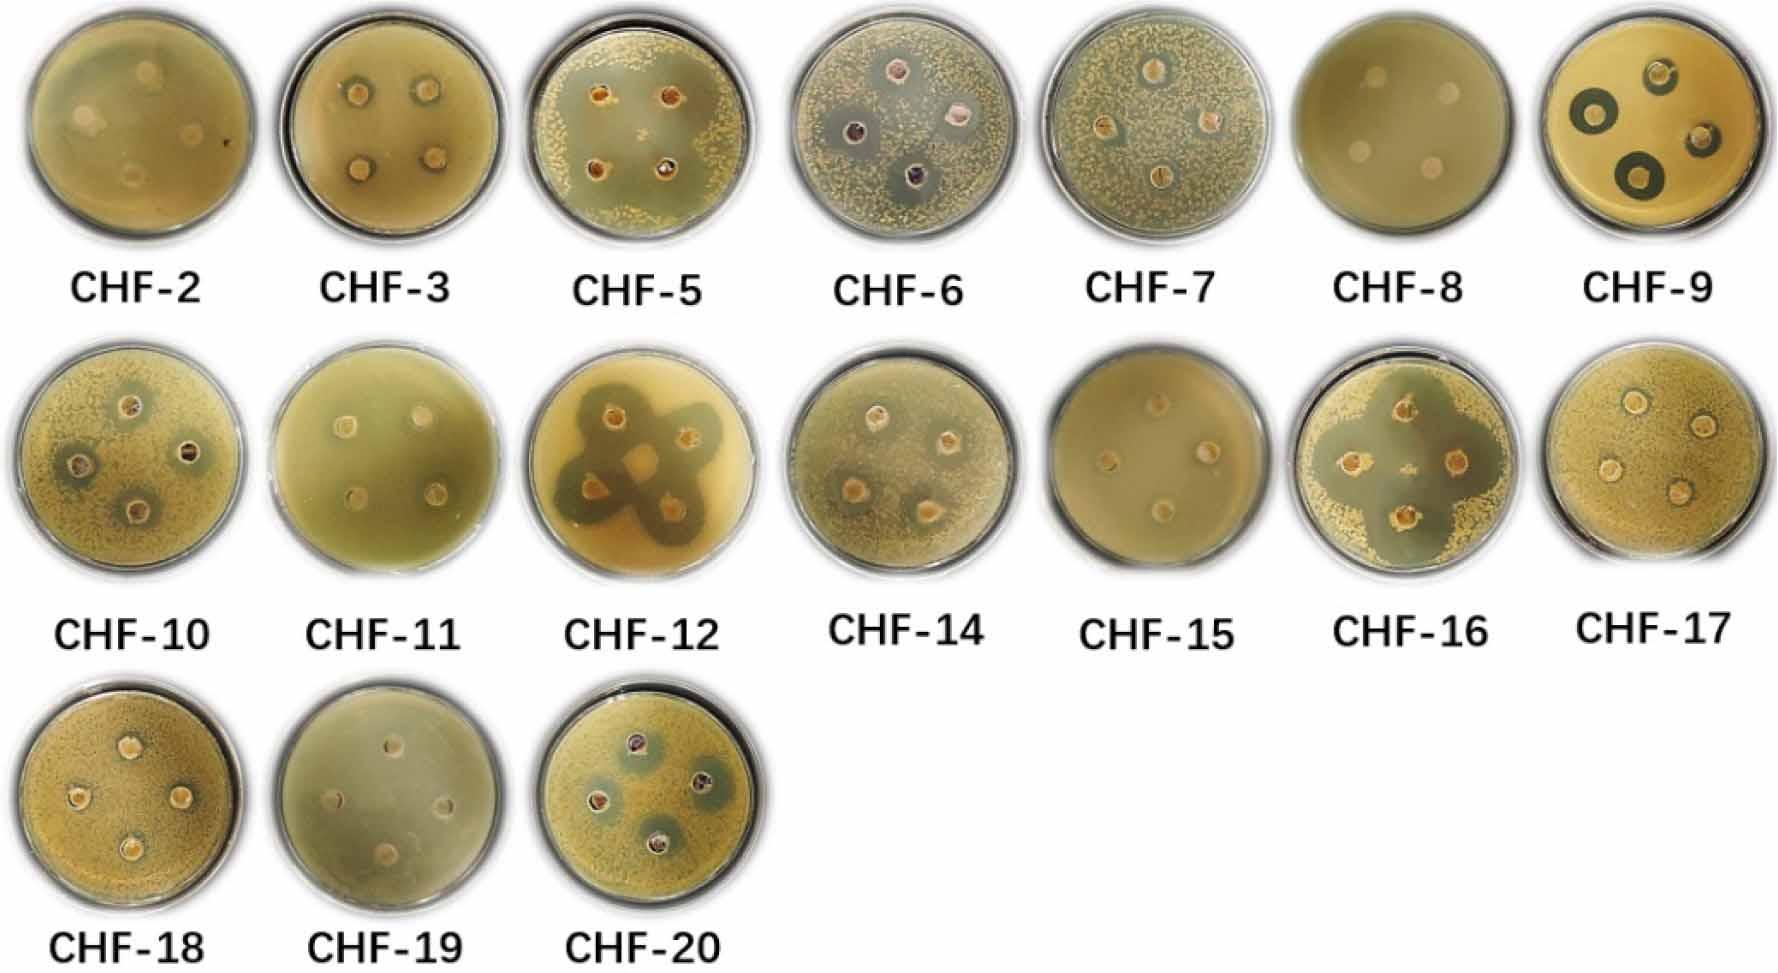

The overuse and misuse of antibiotics have significantly contributed to the rising incidence of antibiotic resistance (AMR), which has now become a chronic global public health issue (Nelson et al. 2019; Larsson et al. 2023; Tang et al. 2023). Antibiotic resistance occurs when viruses, bacteria, fungi, and parasites fail to respond to antimicrobial treatments in humans and animals, thereby allowing these microorganisms to survive within the host (Hinchliffe et al. 2018; Inoue et al. 2019; EFSA Panel on Biological Hazards et al. 2021). These microorganisms possess the remarkable ability to rapidly adapt to environmental changes through mechanisms such as mutation and lateral gene transfer. It not only exacerbates antibiotic resistance but also, due to the widespread use of antibiotics, exerts intense selective pressure on microbial communities, thereby accelerating the evolution of resistance (Michael et al. 2014; Srivastava et al. 2014; Viswanathan et al. 2015). Consequently, the search for antimicrobial-active strains and novel structural compounds holds significant promise for the discovery and development of new antibiotics (Moo et al. 2020; Yang et al. 2021; Urban-Chmiel et al. 2022; Darby et al. 2023; Ramzan et al. 2024) Most antibiotics are naturally produced by microorganisms such as saprophytic bacteria or environmental fungi, while others are semi-synthetic modifications of natural compounds, and a small number are entirely synthetic, like fluoroquinolones and sulfonamides (Niu et al. 2019; Priyanto et al. 2024; Semenzato et al. 2024; Hassen et al. 2025). In clinical settings, common pathogens include Staphylococcus aureus, Proteus vulgaris, and Candida albicans (Singh et al. 2011; Priyanka et al. 2015; Lee et al. 2017). S. aureus is notorious for causing skin infections, such as furunculosis, as well as severe conditions like pneumonia, sepsis, and bacteremia, which are associated with high mortality rates (Foster 2004). Reports indicate that S. aureus is increasingly resistant to vancomycin, highlighting the growing challenge of bacterial resistance to multiple antibiotics (Levy et al. 1998; Chambers et al. 2009; Alanis 2005). Similarly, Proteus isolates, such as Feglo et al. (2010), exhibit high resistance rates to tetracycline (85%), chloramphenicol (82.5%), trimethoprim-sulfamethoxazole (81%), and ampicillin (77%), further underscoring the escalating threat posed by antibiotic resistance (Church and McKillip 2021; Chinemerem Nwobodo et al. 2022; Larsson et al. 2022). C. albicans, the most common human fungal pathogen, can cause infections ranging from mucosal to systemic, and its resistance to antimicrobial treatments underscores the urgent need to discover new antifungal drugs (Cowen et al. 2002; Pereira et al. 2021; Alvarez et al. 2025).
The Helan Mountains, located in Ningxia Province, span over 150,000 square kilometers. Situated in a typical continental climate zone, they exhibit distinct mountain-climate characteristics. The study area has an annual precipitation of 200–400 mm, with an aridity index (AI) < 0.2 (extremely arid). Soil pH in lichen habitats ranges from 8.5 to 10.3 (alkaline), and surface soil NaCl content reaches 15–30 g/kg in dry seasons (Wu et al. 2021; Wang et al. 2024). With their diverse ecological environment and complex geological background, the Helan Mountains have fostered a rich and unique lichen community. These lichens thrive in high-altitude regions and serve as important indicators of environmental changes. We have added a clear research hypothesis: “Endophytes isolated from lichens in the Helan Mountains, an extreme environment characterized by high aridity, intense UV radiation, and periodic soil salinization/alkalization, harbor unique microbial taxa with enhanced antimicrobial activity and salt/alkali tolerance, which are adaptive traits shaped by their harsh ecological niches.” Leveraging the rich and distinctive soil resources and microbial growth characteristics of Ningxia, our research group conducted relevant studies. We selected S. aureus, P. vulgaris, and C. albicans as test strains and used NaCl and NaOH to simulate salt and alkali conditions. We then screened the antimicrobial activity of microorganisms isolated from lichens and tested their salt and alkali resistance. This work lays a foundation for identifying new strains with antimicrobial activity and salt/alkali tolerance, as well as exploring novel structurally active compounds.
Lichen samples were collected from the border region of Ningxia Province, located between 105°57’E and 106°32’E longitude, and 38°16’N and 39°30’N latitude. Sterile techniques were strictly employed during the sampling process to ensure contamination-free collection. The collected specimens were immediately sealed in sterile bags and stored at 4°C to preserve their integrity. These samples were then transported to the Key Laboratory of Chemical Engineering Technology, School of Chemistry and Chemical Engineering, North Minzu University, where they were kept for the isolation and cultivation of microbial strains.
Lichen samples were first cleaned to remove any visible impurities. Approximately 1 gram of each sample was weighed and ground to a powder in a mortar and pestle. Sterile water was then added to prepare lichen suspensions with dilutions of 10−1, 10−2, 10−3, and 10−4. A volume of 0.5 ml of each suspension was transferred onto a Gause No.1 agar plate containing potassium dichromate. The suspension was evenly spread across the surface using a spreader, air-dried, and subsequently incubated at 30°C for 3 to 7 days. Single colonies that emerged were selected and streaked onto fresh agar plates to purify the strains. This streaking process was repeated 2 to 3 times to ensure the isolation of pure cultures. The purified strains were then preserved on agar slants at 4°C and stored in a 50% glycerol solution at –20°C for long-term maintenance.
Pure cultures were obtained by streaking the strains onto agar plates and incubating them at 30°C for approximately one week. The initial morphology of the colonies was observed, and images were captured using a high-resolution imaging device with a resolution of 3060 × 4080 pixels. To further examine the microbial growth, a 10 × 10 mm coverslip was inserted at a 45° angle into the colony plate. After incubation at 30°C for 3 to 5 days, the coverslip was carefully removed and cleaned with 75% ethanol. It was then examined under a biological optical microscope at a 10 × 40 magnification, and images were captured for detailed morphological analysis. To identify the most representative images, capture at least of 3 to 5 photos.
The 16S rDNA was selected as a gene encoding the component of the ribosomal molecule, with a sequence length of approximately 1.5 kb. Sequencing was conducted through Shenzhen Wekemo Technology Group Co., Ltd. Shenzhen China.
- (1)
Bacterial genomic DNA extraction.
Bacterial culture preparation: Prior to DNA extraction, each bacterial sample was inoculated into 5 ml LB liquid medium and cultured at 37°C with 200 rpm shaking for 12–16 h, until the OD600 value reached 1.2 (measured using NanoDrop™ 2000 Spectrophotometer (Thermo Scientific™, Thermo Fisher Scientific Inc., USA)) to ensure sufficient biomass (≈1.0 × 109 cells/ml). Cell harvesting: 1 ml of the above bacterial culture was transferred to a 2 ml centrifuge tube, centrifuged at 12,000 × g for 30 s at room temperature. The supernatant was carefully aspirated using a 1 ml pipette to remove residual medium, and the cell pellet was resuspended in 150 μl Buffer S (pre-supplemented with RNase A to a final concentration of 100 μg/ml) by gentle pipetting (avoiding vigorous vortexing to prevent cell lysis in advance). Cell lysis: 20 μl of lysozyme stock solution (20 mg/ml, freshly prepared in sterile deionized water) was added, mixed by flipping the tube 5 times, and incubated at room temperature for 5 min (we confirmed complete cell wall loosening by observing slight turbidity reduction). Subsequently, 30 μl of 0.25 M EDTA (pH 8.0) was added, mixed gently, and placed on ice for 5 min (with gentle flipping every 1 min to ensure uniform EDTA distribution, which inhibits DNase activity). Protein precipitation: 450 μl of Buffer G-A was added, vortexed vigorously for 15 s (until the mixture became homogeneous), and incubated in a 65°C water bath for 10 min (with vortexing for 10 s every 3 min to ensure complete cell lysis, confirmed by the solution turning clear). Then, 400 μl of Buffer G-B and 1 ml of pre-chilled Buffer DV (4°C) were added, shaken vigorously for 10 s, and centrifuged at 12,000 × g for 2 min at 4°C. DNA purification: The upper aqueous phase was discarded, and the interphase precipitate (protein complex) and lower organic phase were retained. 1 ml of pre-chilled Buffer DV was added again, mixed vigorously, and centrifuged at 12,000 × g for 2 min at 4°C to further remove proteins. The lower organic phase (containing DNA) was transferred to a pre-assembled filter (placed in a 2 ml centrifuge tube) and centrifuged at 12,000 × g for 1 min to collect the filtrate. 400 μl of Buffer BV was added to the filtrate and mixed by pipetting. The mixture was transferred to a preparation tube (silica membrane-based), centrifuged at 12,000 × g for 1 min, and the filtrate was discarded. Washing and elution: The preparation tube was returned to the original 2 ml centrifuge tube; 500 μl of Buffer W1 was added, centrifuged at 12,000 × g for 1 min, and the filtrate was discarded. This was followed by two washes with 700 μl of Buffer W2 (each at 12,000 × g for 1 min) to remove residual salts. After the final wash, the preparation tube was centrifuged at 12,000 × g for an additional 1 min to eliminate residual Buffer W2 (critical to avoid salt interference in subsequent PCR). Finally, the preparation tube was transferred to a new 1.5 ml centrifuge tube; 100 μl of pre-warmed (65°C) sterile deionized water (filtered through a 0.22 μm membrane to remove nucleases) was added drop-wise to the center of the silica membrane, incubated at room temperature for 1 min, and centrifuged at 12,000 × g for 1 min to elute genomic DNA. The concentration and purity of the eluted DNA were verified using a NanoDrop™ 2000 (target: OD260/OD280 = 1.8–2.0, concentration ≥ 20 ng/μl) before proceeding to PCR.
- (2)
Bacterial genomic PCR amplification.
Primer and reagent preparation: The 27F (5′-AGAGTTTGATCCTGGCTCAG-3′) and 1492R (5′-GGTTACCTTGTTACGACTT-3′) primers were synthesized by Paisennuo Biotechnology (PAGE-purified) and diluted to 10 μM with sterile deionized water (Table I), aliquots of 50 μl were stored at -20°C to avoid repeated freezing and thawing. TaKaRa LA Taq™ing Buffer. The mixture was centrifuged at 3,000 × g for 10 s and placed in an ABI-2720 thermal cycler for sequencing reactions: 96°C pre-denaturation for 1 min; 35 cycles of 96°C denaturation for 10 s, 50°C annealing for 5 s, and 60°C extension for 4 min; final holding at 4°C. Sequencing instrument operation: The sequencing reaction products were loaded onto an ABI 3730- XL automated sequencer (Applied Biosystems, Thermo Fisher Scientific Inc., USA) equipped with a 50 cm capillary and POP-7 polymer. The instrument was set to a detection wavelength of 550 nm, and raw sequencing data were collected in ab1 format (trace files) and seq (Takara Bio Inc., Japan) polymerase (5 U/μl) and 10 × Buffer (containing 2.5 mM Mg2+) were thawed on ice and kept on ice during use. PCR reaction system assembly: All reagents were added to a 0.2 ml PCR tube (sterile, RNase/DNase-free) on ice in the following order (to prevent non-specific amplification): 39.0 μl of ddH2O, 5.0 μl of 10× Buffer, 1.0 μl of dNTP (10 mM, TaKaRa D4030A), 1.5 μl of 27F primer (10 μM), 1.5 μl of 1492R primer (10 μM), 1.0 μl of genomic DNA (adjusted to 20 ng/μl using ddH2O), and finally 1.0 μl of Taq polymerase (Table II). The tube was gently flicked 5 times to mix, then centrifuged at 3,000 × g for 10 s to collect liquid droplets at the bottom. PCR Program execution: The PCR tube was placed in an ABI-2720 thermal cycler (Applied Biosystems, Thermo Fisher Scientific Inc., USA) (preheated to 95°C). The reaction program was set as follows: pre-denaturation at 95°C for 5 min (to fully denature genomic DNA); 35 cycles of denaturation at 95°C for 30 s (verified by the cycler’s temperature sensor to ensure precise 95°C hold), annealing at 58°C for 30 s (optimized for 27F/1492R primers to avoid primer-dimer formation), and extension at 72°C for 1.5 min (sufficient for amplifying 1.5 kb 16S rDNA fragments); final extension at 72°C for 7 min (to complete strand synthesis) and holding at 4°C until retrieval (Table III). PCR product verification: After amplification, 3 μl of the PCR product was mixed with 0.5 μl of 6× loading buffer, loaded onto a 1% agarose gel (containing 0.5 μg/ml ethidium bromide) with DL2000 DNA Marker (TaKaRa), and electrophoresed at 120 V for 25 min. The gel was visualized under a 302 nm UV transilluminator and only samples showing a single, clear band at ≈1,500 bp (consistent with the expected size of 16S rDNA) were used for subsequent product recovery.
- (3)
Sequence Determination and Analysis.
Sequencing template preparation: The purified PCR products were first subjected to a pre-sequencing purification step to remove residual primers and dNTPs: 2 μl of ExoSAP-IT enzyme (Thermo Fisher Scientific Inc., USA) was added to 5 μl of the purified PCR product, incubated at 37°C for 15 min (to digest primers/dNTPs), and then at 80°C for 15 min (to inactivate the enzyme). Sequencing reaction setup: The sequencing reaction was performed in a 10 μl system: 5 μl of ExoSAP-IT-purified PCR product, 1 μl of 5 μM sequencing primer (27F or 1492R, for bidirectional sequencing to improve sequence accuracy), 2 μl of BigDye Terminator v3.1 (Applied Biosystems, Thermo Fisher Scientific Inc., USA), and 2 μl of 5× Sequenc-format (base call files). Sequence quality control and assembly: The ab1 files were visualized using Chromas v2.6.6 software to assess sequence quality: low-quality bases (Phred score < 20) at the 5’ end (first 20 bp) and 3’ end (last 15 bp) were trimmed. Bidirectional sequences (from 27F and 1492R) of the same sample were assembled using SeqMan 7.1.0 software (Lasergene) to generate a consensus sequence (minimum overlap length: 300 bp, overlap identity: ≥ 98%). Species identification via BLAST: The assembled consensus sequences were uploaded to the NCBI BLASTn platform (https://blast.ncbi.nlm.nih.gov), with parameters set as follows: Database = “16S ribosomal RNA sequences (Bacteria and Archaea)”, Program Selection = “megablast” (for high-similarity alignment), Max target sequences = 10. The species with the highest similarity (≥ 97%, per bacterial taxonomy standards) and sequence coverage ≥ 95% was selected as the final identification result. For samples with ambiguous results (e.g., “double peaks” in Z4712-5), we repeated the PCR and sequencing steps with three biological replicates to confirm whether the ambiguity originated from template impurity (rather than technical error).
Primer design.
| Primer name | Sequence |
|---|---|
| 27F | 5′-AGAGTTTGATCCTGGCTCAG-3′ |
| 1492R | 5′-GGTTACCTTGTTACGACTT-3′ |
PCR Amplification Reaction System.
| Reagent | Volume |
|---|---|
| Genomic DNA (20 ng/μl) | 1.0 μl |
| 10× Buffer (containing 2.5 mM Mg2+) | 5.0 μl |
| Taq Polymerase (5 U/μl) | 1.0 μl |
| dNTP (10 mM) | 1.0 μl |
| 27F Primer (10 μM) | 1.5 μl |
| 1492R Primer (10 μM) | 1.5 μl |
| ddH2O | 39.0 μl |
| Total volume | 50.0 μl |
Polymerase Chain Reaction (PCR) Amplification Protocol.
| Pre-denaturation | Denaturation | Annealing | Extension | Final extension | Number of cycles |
|---|---|---|---|---|---|
| 95°C, 5min | 95°C, 30s | 58°C, 30s | 72°C, 1min 30s | 72°C, 7min | 35 |
The sequences of the strains were aligned using the BLAST program available in the NCBI (https://www.ncbi.nlm.nih.gov) database, the phylogenetic tree was constructed using MEGA 7.0.26, the specific parameter configurations are outlined as follows: when utilizing the blastn option in the NCBI BLAST program, the input sequence must adhere to the FASTA format without any spaces between sequences. The “Database” parameter was set to “Standard databases (nr etc.)”, and the “Optimize for” parameter configured to “Highly similar sequences (megablast)”. During the “Construct/Test Neighbor-Joining Tree” procedure in MEGA, the “Test of Phylogeny” parameter was set to the “Bootstrap method”, with the “No. of Bootstrap Replications” parameter adjusted to 1000. Additionally, the “Model/Method” parameter was selected as the “Kimura 2-parameter model”. During sequence alignment, the strain’s genus was determined by identifying one or more sequences exhibiting the highest similarity to the submitted sequence.
Indicator strains, including S. aureus (CG-MCC1.6740), P. vulgaris (CGMCC 1.1651), and C. albicans (CMCC 98001), provided by the School of Pharmacy, Ningxia Medical University, were cultured in LB liquid medium at 37°C with shaking for 12–16 hours. The bacterial concentration was adjusted to 1 × 107 – 1 × 108 CFU/ml using the plate count method.
The antimicrobial activity of the strains was evaluated using the methods described previously (Luo et al. 2021; Wang et al. 2022). Four agar plugs, each with a diameter of 8 mm, were prepared from 7-day-old cultures. Holes were created in PDA (Potato Dextrose Agar) and nutrient agar plates, and the agar plugs were placed into these holes. Indicator strains were then inoculated onto the plates at a dilution of 1:100 and incubated at 37°C for 12 to 24 hours and three parallel control groups were established. The diameters of the resulting inhibition zones were measured and photographed.
The pH of the culture medium was adjusted to 7.0, and sodium chloride (NaCl) was added to achieve concentrations of 25, 50, 75, and 100 g/l. The isolated strains were inoculated onto these media and incubated at 30°C for 7 days. To minimize potential errors and mitigate the effects of chance, three parallel control groups were established. Colony growth was monitored, and strains that exhibited strong salt tolerance were selected and photographed.
The salinity of the culture medium was maintained at normal levels, and the pH was adjusted to 8.0, 9.0, 10.0, and 11.0 by adding a 1 mol/l NaOH solution. The isolated strains were inoculated onto these media and incubated at 30°C for 7 days. To minimize potential errors and mitigate the effects of chance, three parallel control groups were established. Colony growth was observed, and strains that demonstrated strong alkaline tolerance were selected and photographed.
Seventeen distinct strains were isolated from lichen samples collected at the base of the Helan Mountains, and their identities were subsequently confirmed. The morphologies of these colonies are illustrated in Fig. 1. The majority of the colonies were small and dense, with a relatively dry surface that adhered tightly to the growth medium, making them difficult to manipulate with an inoculating loop. In contrast, a few strains displayed a moist, smooth surface, which facilitated easy picking. The metabolites produced by these strains exhibited variations in color and shape, with subtle differences observed between the front and back sides of the colonies. Imaging was conducted using a 10 × 40 biological optical microscope, as shown in Fig. 2. Most strains exhibited well-developed mycelium, characterized by branched, filamentous structures. However, a few strains exhibited different growth patterns: strains CHF-8 and CHF-11 formed reticular (net-like) structures; CHF-14 and CHF-19 developed nearly spherical colonies, which appeared either singly or in pairs; and CHF-17 displayed dense branching with an abundance of sporangia.

The front and back morphology of 17 bacterial colonies.

Morphological diagram of 17 bacterial strains.
The 16S rRNA gene sequences of the strains were determined and compared with reference sequences in the NCBI database to identify the species with the highest similarity (Table IV). It is widely accepted that a 16S rRNA gene sequence similarity of over 97% indicates that the strains belong to the same species. The results showed that all 17 strains had 16S rRNA gene sequences that were 97% or more similar to their respective reference sequences. Based on these comparisons, the strains were classified into five genera: 13 strains of Streptomyces, 1 strain of Niallia, 1 strain of Acinetobacter, 1 strain of Peribacillus, and 1 strain of Pseudoclavibacter. A phylogenetic tree was constructed using the Neighbor-Joining (NJ) method to illustrate the evolutionary relationships among the strains. The optimal tree with the sum of branch length = 4.67325812 is shown (Fig. 3). The percentage of replicate trees in which the associated taxa clustered together in the bootstrap test (1,000 replicates) is shown next to the branches. The evolutionary distances were computed using the p-distance method and are expressed as the number of base differences per site. The analysis involved 17 nucleotide sequences. All positions with less than 50% site coverage were eliminated. That is, fewer than 50% alignment gaps, missing data, and ambiguous bases were allowed at any position. There were a total of 1398 positions in the final dataset. The bootstrap values at the nodes indicate the confidence levels of the phylogenetic groupings, with higher values suggesting closer evolutionary relationships. Further analysis of the phylogenetic tree revealed the following relationships: Streptomyces strains CHF-6 and CHF-20, CHF-5 and CHF-16, and CHF-7 and CHF-18 had bootstrap values of 100%, indicating very close evolutionary relationships. Strains CHF-8 and CHF-14 exhibited a high degree of relatedness, as did strains CHF-9, CHF-12, and CHF-2. These findings provide valuable insights into the phylogenetic relationships of the isolated strains and their potential taxonomic classifications.

Phylogenetic tree constructed based on 16S rRNA gene sequences.
The values at the branch points are the bootstrap values calculated 1,000 times when constructing the phylogenetic tree; the scale 0.05 represents a 5% difference in calculations.
Identification results of 17 bacterial strains.
| Strain No. | Scientific name | Query coverage | Identities | Sequence ID |
|---|---|---|---|---|
| CHF-2 | Streptomyces heliomycini | 100% | 99.22% | NR_041197.1 |
| CHF-3 | Streptomyces plumbiresistens | 100% | 99.21% | NR_044518.1 |
| CHF-5 | Streptomyces alfalfae | 100% | 98.79% | NR_147713.1 |
| CHF-6 | Streptomyces huasconensis | 100% | 100.00% | NR_178969.1 |
| CHF-7 | Streptomyces spiroverticillatus | 100% | 99.50% | NR_112582.1 |
| CHF-8 | Niallia nealsonii | 100% | 99.22% | NR_044546.1 |
| CHF-9 | Streptomyces alfalfae | 100% | 98.71% | NR_147713.1 |
| CHF-10 | Streptomyces kanamyceticus | 99% | 98.88% | NR_043822.1 |
| CHF-11 | Acinetobacter seifertii | 100% | 100.00% | NR_134684.1 |
| CHF-12 | Streptomyces alfalfae | 98% | 97.99% | NR_147713.1 |
| CHF-14 | Peribacillus frigoritolerans | 100% | 99.93% | NR_117474.1 |
| CHF-15 | Streptomyces alboniger | 100% | 99.35% | NR_043228.2 |
| CHF-16 | Streptomyces alfalfae | 100% | 97.59% | NR_147713.1 |
| CHF-17 | Streptomyces spiroverticillatus | 100% | 99.43% | NR_112582.1 |
| CHF-18 | Streptomyces spiroverticillatus | 100% | 99.50% | NR_112582.1 |
| CHF-19 | Pseudarthrobacter siccitolerans | 100% | 99.50% | NR_108849.1 |
| CHF-20 | Streptomyces aureus | 99% | 99.06% | NR_025663.1 |
Antimicrobial assays against S. aureus revealed that 14 strains exhibited varying degrees of antibacterial or inhibitory activity. These included 12 Streptomyces strains, one Acinetobacter seifertii strain, and one Peribacillus strain, as shown in Fig. 4. Specifically, the active Streptomyces strains were CHF-3, CHF-5, CHF-6, CHF-7, CHF-9, CHF-10, CHF-12, CHF-15, CHF-16, CHF-17, CHF-18, and CHF-20; the A. seifertii strain was CHF-11; and the Peribacillus strain was CHF-14. These results suggest that the strains derived from lichens may produce secondary metabolites with inhibitory effects against S. aureus.
Inhibitory activity of secondary metabolites of 17 strains against Staphylococcus aureus.
Antimicrobial assays against P. vulgaris indicated that eight strains exhibited antibacterial or inhibitory activity, including 6 Streptomyces strains, one A. seifertii strain, and one Peribacillus strain, as shown in Fig. 5. The active Streptomyces strains were CHF-3, CHF-9, CHF-11, CHF-12, CHF-15, and CHF-16; the A. seifertii strain was CHF-11; and the Peribacillus strain was CHF-14. These findings suggest that the isolated strains have the potential to produce secondary metabolites with inhibitory effects against P. vulgaris.

Inhibitory activity of secondary metabolites of 17 strains against Proteus vulgaris.
Antimicrobial assays against C. albicans revealed that six strains exhibited varying degrees of antibacterial or inhibitory activity, including 4 Streptomyces strains, one A. seifertii strain, and one Peribacillus strain, as shown in Fig. 6. The active Streptomyces strains were CHF-3, CHF-6, CHF-17, and CHF-18; the A. seifertii strain was CHF-11; and the Peribacillus strain was CHF-14. These results suggest that the lichen-derived strains may produce secondary metabolites with inhibitory effects against C. albicans.

Inhibitory activity of secondary metabolites of 17 strains against Candida albicans.
Collectively, these antimicrobial screening experiments and control assays indicate that the Streptomyces strains and other genera isolated from the lichens produce secondary metabolites with varying degrees of inhibitory effects against Gram-positive bacteria, Gram-negative bacteria, and fungi. This suggests that the secondary metabolites of these strains contain bioactive compounds with antimicrobial properties, highlighting their potential for further development and research.
The antimicrobial activity of 17 bacterial strains against three indicator strains was assessed using the agar plug colonization method. The results indicated that most strains exhibited distinct inhibition zones. In the assay against S. aureus, inhibition zones were precisely measured for 14 strains: CHF-3 (1.52 cm), CHF-5 (4.25 cm), CHF-6 (2.27 cm), CHF-7 (1.49 cm), CHF-9 (1.78 cm), CHF-10 (2.11 cm), CHF-11 (1.62 cm), CHF-12 (3.34 cm), CHF-14 (2.14 cm), CHF-15 (1.20 cm), CHF-16 (4.14 cm), CHF-17 (1.49 cm), CHF-18 (1.47 cm), and CHF-20 (2.20 cm). These findings suggest that the secondary metabolites of these strains possess antimicrobial activity against S. aureus. Notably, strains CHF-5, CHF-12, and CHF-16 exhibited significant inhibitory effects under the experimental conditions, with inhibition zone diameters exceeding 3 cm.
In the assay against P. vulgaris, inhibition zones were observed for eight strains: CHF-3 (1.56 cm), CHF-9 (1.55 cm), CHF-11 (1.53 cm), CHF-12 (3.35 cm), CHF-14 (1.50 cm), CHF-15 (2.73 cm), CHF-16 (2.37 cm), and CHF-18 (1.37 cm). This indicates that their secondary metabolites have moderate antimicrobial activity. Among these, CHF-12 displayed a powerful inhibitory effect, with an inhibition zone diameter greater than 3 cm. In the assay against C. albicans, six strains—CHF-3 (1.55 cm), CHF-6 (2.52 cm), CHF-11 (1.54 cm), CHF-14 (1.53 cm), CHF-17 (1.72 cm), and CHF-18 (1.69 cm)—showed detectable inhibition zones. This suggests the presence of antifungal compounds in their secondary metabolites. Strain CHF-6 demonstrated particularly strong activity against C. albicans. No significant inhibition zones were observed for the remaining strains at an inoculum concentration of 107−108 CFU/ml. Detailed inhibition zone diameters are summarized in Table V.
Results of inhibition zone determination of antibacterial activity of strains.
| Strain No. | Bacteriostatic diameter/cm | ||
|---|---|---|---|
| Staphylococcus aureus | Proteus vulgaris | Candida albicans | |
| CHF-2 | – | – | – |
| CHF-3 | 1.52 | 1.56 | 1.55 |
| CHF-5 | 4.25 | – | – |
| CHF-6 | 2.27 | – | 2.52 |
| CHF-7 | 1.49 | – | – |
| CHF-8 | – | – | – |
| CHF-9 | 1.78 | 1.55 | – |
| CHF-10 | 2.11 | – | – |
| CHF-11 | 1.62 | 1.53 | 1.54 |
| CHF-12 | 3.34 | 3.35 | – |
| CHF-14 | 2.14 | 1.50 | 1.53 |
| CHF-15 | 1.20 | 2.73 | – |
| CHF-16 | 4.14 | 2.37 | – |
| CHF-17 | 1.49 | – | 1.72 |
| CHF-18 | 1.47 | 1.37 | 1.69 |
| CHF-19 | – | – | – |
| CHF-20 | 2.20 | – | – |
“–” in the table means that the strain did not produce obvious inhibition zone against the test bacteria at a concentration of 107–108 CFU/ml
Sodium chloride (NaCl), a commonly used laboratory reagent and an essential component for strain isolation and culture, was selected as the test salt. Four gradient concentrations of NaCl (25, 50, 75, and 100 g/l) were prepared by adding different amounts of NaCl to the culture medium. The salt tolerance of the 17 strains was evaluated by culturing them at these concentrations at 30°C for 7 days. The results are presented in Fig. 7.

Test results of salt tolerance of 17 bacterial strains.
The results indicated that most of the 17 strains exhibited weak salt tolerance. Strains CHF-11, CHF-15, and CHF-18 were able to grow across all four NaCl concentrations, although their growth was suboptimal. The remaining strains showed inhibited growth at specific concentrations. This demonstrates that while NaCl is a necessary nutrient for microbial growth, it can become inhibitory at excessive levels. Detailed statistical results are summarized in Table VI.
Salt tolerance of 17 bacterial strains.
| Strain No. | NaCl concentration (g/l) | |||
|---|---|---|---|---|
| 25 | 50 | 75 | 100 | |
| CHF-2 | + | + | + | – |
| CHF-3 | + | – | – | – |
| CHF-5 | + | – | – | – |
| CHF-6 | + | + | + | – |
| CHF-7 | + | – | + | – |
| CHF-8 | + | – | – | – |
| CHF-9 | + | – | – | – |
| CHF-10 | + | – | – | – |
| CHF-11 | + | + | + | + |
| CHF-12 | + | – | – | – |
| CHF-14 | + | + | + | – |
| CHF-15 | + | + | – | + |
| CHF-16 | + | – | – | – |
| CHF-17 | + | + | – | – |
| CHF-18 | + | – | + | + |
| CHF-19 | + | – | + | – |
| CHF-20 | + | + | – | – |
“+” strain grew, “–” strain did not grow
Sodium hydroxide (NaOH) was chosen as the test alkali. The pH of the culture medium was adjusted to 8, 9, 10, and 11 by adding a 1 mol/l NaOH solution. The alkaline tolerance of the 17 bacterial strains was assessed, and the results are shown in Fig. 8.

Test results of alkali resistance of 17 bacterial strains.
The results revealed that the 17 strains exhibited strong alkali resistance. Fourteen grew across all four pH values. Strain CHF-18 grew at pH 8 and 11 but not at pH 9 or 10, suggesting a relationship to its unique growth characteristics. Overall, the results indicate that these strains possess good alkali tolerance under the tested conditions. Detailed statistical results are summarized in Table VII.
Alkali resistance of 17 bacterial strains.
| Strain No. | pH | |||
|---|---|---|---|---|
| 8 | 9 | 10 | 11 | |
| CHF-2 | + | + | + | + |
| CHF-3 | + | + | + | + |
| CHF-5 | + | + | + | + |
| CHF-6 | + | + | + | + |
| CHF-7 | + | + | + | + |
| CHF-8 | + | + | + | – |
| CHF-9 | + | + | + | + |
| CHF-10 | + | + | + | + |
| CHF-11 | + | + | + | + |
| CHF-12 | + | + | + | + |
| CHF-14 | + | + | + | + |
| CHF-15 | + | + | + | + |
| CHF-16 | + | + | + | + |
| CHF-17 | + | + | + | + |
| CHF-18 | + | – | – | + |
| CHF-19 | + | – | – | – |
| CHF-20 | + | + | + | + |
“+” strain grew, “-” strain did not grow
Previous research has established that secondary metabolites produced by Streptomyces species are a significant source of antibiotics. For instance, the water-soluble antibiotics produced by a Streptomyces strain isolated by Higginbotham and Murphy (2010) exhibit broad-spectrum activity, particularly demonstrating strong efficacy against clinical isolates of methicillin-resistant S. aureus (MRSA), which constitute the main clonal complex. Similarly, the ethyl acetate extract of a Streptomyces strain isolated by Valan et al. (2009) has shown strong inhibitory activity against both S. aureus and C. albicans. Manimaran et al. (2017) isolated a novel actinomycete strain, Streptomyces sp., that produces antibacterial compounds. Two bioactive compounds extracted from this strain have been found to exhibit pathogenic or toxic effects in humans, multidrug resistance, and vigorous activity against C. albicans. Additionally, the volatile organic compounds (VOCs) produced by a Streptomyces strain isolated by Ayed et al. (2022) have been shown to completely inhibit the growth of C. albicans under specific conditions.
In this study, 17 strains were isolated and purified from lichens collected in the Helan Mountains. These included 13 strains of Streptomyces, 1 strain of Niallia, 1 strain of Acinetobacter, 1 strain of Peribacillus, and 1 strain of Pseudarthrobacter. The FASTQ files from 16S rRNA sequencing have been submitted to the NCBI SRA database under accession PRJNA1328199.
Antibacterial activity tests were conducted using S. aureus, P. vulgaris, and C. albicans as indicator strains. The results indicated that 14 of the isolated strains exhibited antibacterial activity. Additionally, salt and alkali resistance tests revealed that 3 strains showed salt tolerance, while 14 strains demonstrated strong alkali resistance. These findings suggest that the secondary metabolites produced by these strains contain bioactive compounds with antibacterial properties. This highlights the potential of lichen-derived strains from the Helan Mountains as a source for discovering new antibacterial agents and structurally novel compounds, thus laying a foundation for further exploration and research in this area.